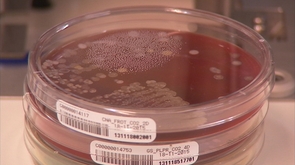

Le CHU de Liège doit traiter de plus en plus d'échantillons de bactériologie. Pour répondre à la demande et prendre en charge encore plus rapidement les patients, il vient d'investir deux millons d'euros dans une chaîne de bactériologie automatisée. Après une période de validation, elle vient d'entrer pleinement en activité.